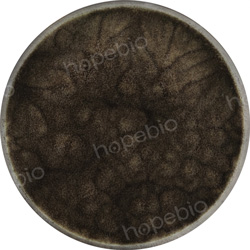

用途:用于塑料防腐剂的防腐效果评估中霉菌培养。
成分(g/L)
|
麦芽提取物
|
30.0
|
|
大豆蛋白胨
|
3.0
|
|
琼脂
|
15.0
|
|
pH值7.0±0.2
|
25℃
|
检验原理:
麦芽提取物为微生物的生长提供碳源和生长因子,含有可发酵的糖类;大豆蛋白胨可提供氮源和生长因子;琼脂是培养基的凝固剂。
用法:
称取本品48.0g,加热煮沸完全溶解于1000ml蒸馏水中,分装试管或三角瓶,121℃高压灭菌15分钟,备用。
麦芽提取物琼脂(GB/T24128-2018)微生物质控结果:
|
黑曲霉
CMCC 98003
|
|

|
|
参比SDA
|
麦芽提取物琼脂
|
麦芽提取物琼脂(GB/T24128-2018)微生物灵敏度试验:
按标签用法制备培养基,接种以下质控菌株,放置25℃需氧培养72小时。
注:回收率计算时,用SDA琼脂做对照培养基。

相关资料:
麦芽提取物琼脂的原理及使用方法 点击查看
GB/T 24128-2018 塑料 塑料防霉剂的防霉效果评估 点击查看


 海博微信公众号
海博微信公众号
 海博天猫旗舰店
海博天猫旗舰店


 海博微信公众号
海博微信公众号
 海博天猫旗舰店
海博天猫旗舰店






